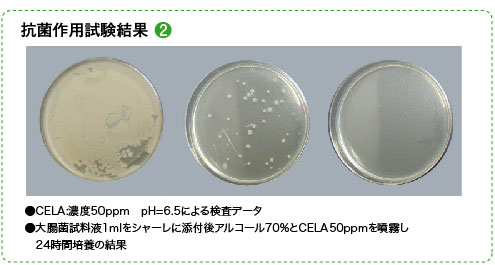

CELAセラとは!?弱酸性次亜塩素酸水とは!?

除菌と消臭及びウィルス対策を基本に考えて作られた新世代の弱酸性次亜塩素酸水です。弱酸性次亜塩素酸水は、人体に影響の少ない弱酸性(pH6.5)の状態で有効塩素の比率が高い(=除菌力の高い)水です。生成段階で有害な塩素ガスの発生もなく、排水時に特別な処理も必要としない環境にやさしい水です。
Clean (クリーン) + Ecology (エコロジー) + Life (ライフ) + Antivirus (アンチウィルス)
それぞれの単語の頭文字をとってCELAセラなのです。
※「CELA」と「Clean Water CELA」はミツヤテック株式会社の登録商標です。六感はミツヤテック社と保守管理及び販売の契約をおこなっております。
次亜塩素酸水とは厚生労働省の定義によると、「殺菌科の一種であり、塩酸又は食塩水を電解することに得られる次亜塩素酸を主成分とする水溶液」である。わが国では平成14年6月に、食品添加物として指定されており、使用基準及び成分規格が定められている。
世の中には数多くの次亜塩素酸水と謳った商品があります。その中で「どれを選んだらいいの?」と多くの方が悩んでいます。インターネット上で次亜塩素酸水を検索すると濃度の違う様々な商品(おおよそ10〜500ppm)がヒットします。濃度が高いほど希釈して使えるのでお得ではないのか?!と思ってしまいがちですが、ちょっと待って下さい!実は高濃度の方が成分が安定せず分離する確率が高く、輸送時などの衝撃による分裂が起こります。このため濃度の高い次亜塩素酸水は成分の安定性が低く、劣化が早いとされています。では、どの次亜塩素酸水を選べばいいのか!?
NITE(独立行政法人 製品評価技術基盤機構)による次亜塩素酸水についての見解と解説
令和2年6月26日、NITE(ナイト)独立行政法人 製品評価技術基盤機構より次亜塩素酸水の新型コロナウイルスに対する消毒方法の有効性の確認が発表されました。弊社にて製造・販売しているCELAセラも有効性が認められる範囲に収まっています。発表内容の詳細は、https://www.nite.go.jp/information/osirase20200626.htmlでご確認下さい。
今回の次亜塩素酸水が有効である発表について、メディアが全くと言っていいほど情報を発信しません。それは前回の中間報告で「効果が無い」「危険」を散々報道した結果、全くの間違いであったからです。しかも前回の中間報告の資料をしっかり読めば「効果があることがはっきり記載されていますし、NITE(ナイト)独立行政法人 製品評価技術基盤機構もホームページで”「有効性がない」かのような内容を弊機構が公表していると誤解しうる報道も一部にありますが、そうした事実はありません。”と記載しているにもかかわらず、訂正報道をしたり、今回の有効性確認の報道をしないということは、メディアが正しくメディアの役割をしていないということになります。
pHやppmなどの基礎知識を持ち合わせていない一般ユーザーに「どの情報が正しいのか」を選択できるように、メディアに代わって少しでもわかりやすく解説できればと思います。
■引用記事及び参照資料先について
・NITE(ナイト)独立行政法人製品評価技術基盤機構
https://www.nite.go.jp/information/osirase20200626.html
・一般社団法人次亜塩素酸水普及促進会議
https://akarimirai.com/jia/index.html#home
NITE(独立行政法人 製品評価技術基盤機構)による次亜塩素酸水の有効性について
令和2年6月26日にNITE(ナイト)独立行政法人 製品評価技術基盤機構より次亜塩素酸水の新型コロナウイルスに対する消毒方法の有効性の確認が発表されました。代替消毒方法の有効性評価の報告の概要になります。


政府が既に推奨している消毒方法のアルコール消毒薬も塩素系漂白剤も、今回追加されて代替可能となった界面活性剤も次亜塩素酸水も人体に対しての安全性ではなく新型コロナウイルスに対しての有効性のみの試験と発表しています。決して有効性=安全性ではありません。有効性のあるすべての対象に「使用に当たっては、製造事業者等が提供する 安全情報や使用上の注意等を十分に踏まえて、 適切にご使用ください。」の表記が付属しています。安全性は製造事業者等が提供する情報や使用上の注意等を十分に踏まえて、各々の判断でご使用下さいという事になり、国は関与しませんという事になります。だから人体には使用しないように注意喚起しているのです。
上記より弊社にて製造・販売している『CELAセラ』(pH6.5/有効塩素濃度50ppm)も有効性が認められる範囲に収まっています。
次亜塩素酸水の有効性かつ安全性を追及するには
新型コロナウイルスに有効な使用方法で最も重要なのはウイルスと次亜塩素酸水の接触時間です。流水の方が新鮮な次亜塩素酸水との接触時間が長いので塩素濃度が低くても効果が認められるということです。NITEの中間報告の時点でも既に49ppmの次亜塩素酸水で、たったの20秒で99.9%以上、1分で99.99%以上の除菌効果が確認されています。(国立感染症研究所の検証試験において)また、有効性が少なかった次亜塩素酸水も量を増やしてウイルスと接触させることで有効性が確認されています。
一般的に、人やペットなど生き物に対しては80ppmまでが安全の限度とされ、80ppmを超える濃度の次亜塩素酸水を使う場合は医師など専門家の指導のもとで使用してください。50ppmでも効果はあるの?と疑問に思われる方もいるかもしれませんが、一般的な菌やウイルスは50ppmのCELAセラで必要十分な効果が得られます。
市販されている次亜塩素酸水の中で最も濃度が高いものは500ppm程のものがあります。しかしこのような高濃度は人体には安全ではないため、ほとんどの市販品は希釈して使用するようにと記載があります。しかしながら、試験データは高濃度のままで使用した場合です。本来であれば希釈した状態での試験データを掲載しなければならない筈ですが、ほとんど見た事がありません。例えば500ppmの高濃度を10倍希釈したら、50ppmになるかと言えば必ずしもなりません。なぜならば希釈する水道水によってもpH及び濃度が変化するので安定したデータとして確定出来ないからです。最終製品の状態のものを実際に使用した安全性試験を行った製品でなければ、正しく安全とは言えません。

確かに100ppmのように高い濃度の方が除菌力は高いかもしれません。しかし、人体に不安だから加減して少量使うという使用方法は効き目が薄いのです。50ppmのCELAセラで効き目が心配なのであれば、1プッシュのところを2プッシュにすれば、それだけで問題は解決です。大切なのは菌と次亜塩素酸水の接触時間です。危険な高濃度を少量使うよりも、安全な低濃度をたっぷり使う方が効果が高い!これが次亜塩素酸水を上手に使うコツです。

たとえば上記の試験の中で、「全身吸引暴露による急性毒性試験」がありますが、これは「スプレーや超音波噴霧器でCELAセラを空中に噴霧した時は、ミストを肺の中に吸い込むことになりますが、その時にどんな悪影響がでるか」という試験になります。結果は「変化は認められない」となり、これは吸い込んで肺に入っても影響がないという証明になります。目に入っても、皮膚に付着しても無刺激ということも証明されています。ぜひ安心して日々の衛生管理にお使いください。
CELAセラは生成した最終製品状態(50ppm pH6.5±0.05)で各種安全性試験をおこない、人体に害が無いことを確認しています。
超音波加湿器による空間噴霧の安全性ついて
令和2年6月13日版のNITE(ナイト)独立行政法人 製品評価技術基盤機構が発表した空間噴霧の内容となります。
今回の有効性評価は、アルコール消毒液の代替となる身の回りの物品の消毒方法の評価が目的であり、空間噴霧は評価対象となっておりません。「次亜塩素酸水」の噴霧での利用は安全面から控えるよう弊機構が公表したとする報道が一部にありますが、噴霧利用の是非について何らかの見解を示した事実はございません。「次亜塩素酸水」を消毒目的で有人空間に噴霧することは、その有効性、安全性ともに、メーカー等が工夫して評価を行っていますが、確立された評価方法は定まっていないと承知しています。メーカーが提供する情報をよく吟味し、ご判断をいただければと存じます。
上記のように厚生労働省からの注意として「次亜塩素酸を含む消毒薬の噴霧については、吸引すると有害であり、効果が不確実であることから行わないこと。」と発表されています。ただし、これは次亜塩素酸ナトリウムのことであり、次亜塩素酸水のことではありません。しかし国は次亜塩素酸水の空中噴霧は推奨していません。「使用は各々の判断に任せます」と説明しています。各々が判断するにあたり、判断材料は何か?それは各社の安全性試験です。
令和2年6月29日にNITEの発表を踏まえた上で、「一般社団法人次亜塩素酸水普及促進会議」が次亜塩素酸水の空間噴霧の効果と安全性を発表しました。

今回の報道では、コロナウイルス対策としての「空間噴霧」は推奨しないと言っているに過ぎません。健康被害が出ているのは、次亜塩素酸ナトリウム(ハイター)を希釈したものを次亜塩素酸水と勘違いして噴霧したケースや高濃度の次亜塩素酸水を噴霧したケースです。弊社で製造・販売したCELAセラを8年前から、冬場の加湿器による常時噴霧、スプレーよる手肌の除菌もおこなっておりますが、健康被害が出たことも、手肌が荒れたという報告は一度もありません。また全身吸入暴露による急性毒性試験だけではなく、眼刺激性試験、急性経口毒性試験、皮膚一次刺激性試験において、経過も含め人体への影響や毒性が認められないことが証明されています。
上記より『CELAセラ』(pH6.5/有効塩素濃度50ppm)は超音波加湿器による空中噴霧を安全に安心してお使い頂けます。
従来の次亜塩素酸水ナトリウムとの違い

従来の塩素系除菌消臭剤とは大きく違い、塩素ガスの発生がなく、直接肌に触れても人体に殆ど影響を及ぼすことがないので安心です。 水素イオン指数の制御を可能にした次亜塩素酸(HCIO)を主成分とする弱酸性水です。
CELAセラは殺菌効果のある次亜塩素酸ナトリウムの欠点をなくし、利点のみを引き出した弱酸性次亜塩素酸水です。従来のカビやまな板等の除菌剤、及びプールや水道水に含まれる次亜塩素酸ナトリウムは取り扱いが危険なばかりでなく、pH12以上の強アルカリ性であり、希釈しpH8前後の希釈次亜水にしなければ次亜塩素酸の殺菌効果が得られません。また、希釈次亜水ではCELAセラの1/8程度の殺菌効果しかありません。CELAセラはpHを6.5程度にした弱酸性水なので、安心して消臭・除菌に利用できます。
CELAセラが選ばれる理由
※pH6.5とは普段ご使用されている化粧品や肌と同じです。

※次亜塩素酸水は除菌に非常に有効な機能水です。有効塩素存在率が100%に近いほど除菌効果がありますが、高すぎると生成時に塩素ガス発生の危険性もあります。逆に安全性を考えた次亜塩素酸ナトリウムを主成分とする塩素系除菌液は、pH(水素イオン指数)を10程度にしています。使用する際は水で希釈しますが、有効塩素比率は20%程度です。
CELAセラは有効塩素比率を100%近くまで高めながらも、塩素ガスが発生する心配がないpH6.5で安定生成される弱酸性水です。菌やウイルスに対し高い除菌効果を発揮し、安全性も高いまったく新しい除菌液です。
※無着色・無臭ですのでアルコール製剤のように臭いが気になる、肌がカサつくといったこともありません。
※取扱いが難しい漂白剤などの次亜塩素酸ナトリウムのように希釈して使用することなく、そのままご使用いただけます。
※次亜塩素酸分子(HOCl)の安定度が、電気分解、希釈混合水方式の次亜塩素酸水とは大きく違いますので、保存性がとても高いです。保存性を実証するためCELAセラでは第三者機関による長期保存試験(6カ月)をおこない、有効塩素濃度が著しく低下しないことを実証。さまざまな分野に安心して利用できます。
※温度を80℃に上げても次亜塩素酸(HOCl)の分子構造は変化せず、安定した状態を保ち、酸性に傾く事はありません。次亜塩素酸ナトリウムに対し、CELAセラは1/3のppm(塩素濃度)にし、55℃の温水を使った同等性試験を第三者機関でおこなった結果、同等の効果が認められました。温水を使い卵の消臭・除菌をおこなう、GPセンターや養鶏所では高い効果と共に、コスト削減も期待できます。
※塩酸が発生しないため水と同程度です。

※殺菌剤や消臭剤の中には、使い方や作り方を誤ると人体に悪影響を及ぼすものも少なくありません。誰もが安心して使え、環境にも悪影響を与えることのないCELAセラは次世代の消臭・除菌液として様々なシーンで活用することができます。